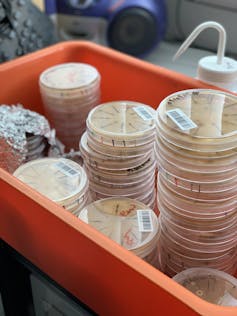

The world is desperate for new antibiotics, and New Zealand's unique fungi are a source of promising compounds
- Written by Siouxsie Wiles, Associate Professor in Microbiology and Infectious Diseases, University of Auckland
While we’re all rightly focused on the COVID-19 pandemic at the moment, the SARS-CoV-2 virus isn’t the only microbial threat we face.
Back in 2014, the World Health Organization (WHO[1]) warned that within a decade, antibiotic-resistant bacteria could make routine surgery, organ transplantation and cancer treatment life-threateningly risky — and spell the end of modern medicine[2] as we know it.
Antibiotics are a cornerstone of modern medicine, used to treat infections and to protect vulnerable patients undergoing surgery or chemotherapy. The world desperately needs new antibiotics and COVID-19 has only exacerbated the problem.
In our search for new antibiotics, we have focused on fungi, especially those found only in Aotearoa New Zealand. Our latest research[4] describes the discovery of fungal compounds able to kill Mycobacteria, a family of slow-growing bacteria that includes another important global airborne killer — Mycobacterium tuberculosis — which causes the lung disease tuberculosis and kills thousands of people around the world each day.
While most people in Aotearoa know me as the “pink-haired COVID lady”, for the past six years my lab has been hunting for compounds that could make good antibiotics. We’ve focused on fungi from the International Collection of Microorganisms from Plants (ICMP[5]), cared for by the Crown Research Institute Manaaki Whenua[6] and our collaborator Bevan Weir[7].
Our latest findings follow earlier research[8] which revealed a fungal compound with some activity against the hospital superbug methicillin-resistant Staphylococcus aureus, better known as MRSA.
Why fungi?
One of the earliest antibiotics ever discovered, penicillin, originally came from a fungus called Penicillium rubens. With more than 10,000 fungi in the ICMP database, we think this may be a treasure trove of potential new antibiotics.
For our latest study[9], we tested 36 fungi collected between 1961 and 2016 from locations right across Aotearoa, including the Chatham Islands. Our first exciting finding is that nine of the fungi are not known species, suggesting they may well be unique to Aotearoa.

Aotearoa is well known for its iconic animal and plant species that aren’t found anywhere else in the world. Our fungi will be no different. And if they are unique, they may have come up with unique compounds able to kill bacteria.
Our second major finding is that 35 of the 36 fungi we tested had some form of antibacterial activity against Mycobacteria. In fact, when we first started doing this work, we thought we must have made a mistake. We’d never had anything like that kind of success rate when screening fungi against other superbugs.
Read more: How we discovered a hidden world of fungi inside the world’s biggest seed bank[11]
Taking a deeper dive into the chemistry of those fungal compounds, we found the majority are fatty acids which won’t make good antibiotics. But we did find several fungi, including two of our unknown species, whose antibacterial activity wasn’t due to fatty acids.
We’re currently working to identify these compounds, with our collaborators Melissa Cadelis[12] and Brent Copp[13].
Long road to discovery
Physicist Jim Al-Khalili once said that most scientific progress is a “messy, complex and slow process”. Take the COVID-19 vaccines as a good example. While we’ve watched numerous vaccines come through clinical trials successfully and quickly, they are based on decades of scientific study[14] of mRNA and lipid nanoparticles.
My lab’s search for antibiotics has its roots in work we did over a decade ago, making tools to make Mycobacteria glow in the dark[15]. Because these bacteria grow so slowly, it can take weeks to months for them to form colonies on a petri dish.
But they glow only when they are alive, and this technique allows us to measure the amount of light they produce instead of waiting for them to grow. This massively speeds up the antibiotic discovery process.
Read more: New technology can create treatment against drug-resistant bacteria in under a week and adapt to antibiotic resistance[16]
I started thinking about fungi as a potential source of new antibacterial compounds when Manaaki Whenua’s fungi expert Peter Buchanan told me about the collection. After a few years of rejected funding applications, we finally got a small grant-in-aid from Cure Kids[17] to get the project started in 2015.
One of their ambassadors, Eva[18], has battled superbug infections her whole life. Meeting Eva changed my relationship with my work and inspired me to do all I can to find new antibiotics.
Eva is a Cure Kids ambassador who lives with MRSA and was born with a hole in her diaphragm.We’ve still got a way to go before we have any compounds that might be suitable for further development as antibiotics. We also know that many compounds fail as they move through the pipeline that takes them from the lab to clinical trials in humans.
That’s why my lab will keep working its way through the fungal collection for as long as we can afford to. There are thousands more fungi to screen and hopefully many more unique compounds with antibiotic potential to discover.
References
- ^ WHO (www.who.int)
- ^ end of modern medicine (abcnews.go.com)
- ^ CC BY-SA (creativecommons.org)
- ^ research (www.frontiersin.org)
- ^ ICMP (www.landcareresearch.co.nz)
- ^ Manaaki Whenua (www.landcareresearch.co.nz)
- ^ Bevan Weir (www.landcareresearch.co.nz)
- ^ earlier research (www.mdpi.com)
- ^ study (www.frontiersin.org)
- ^ CC BY-SA (creativecommons.org)
- ^ How we discovered a hidden world of fungi inside the world’s biggest seed bank (theconversation.com)
- ^ Melissa Cadelis (unidirectory.auckland.ac.nz)
- ^ Brent Copp (unidirectory.auckland.ac.nz)
- ^ decades of scientific study (www.nature.com)
- ^ Mycobacteria glow in the dark (journals.plos.org)
- ^ New technology can create treatment against drug-resistant bacteria in under a week and adapt to antibiotic resistance (theconversation.com)
- ^ Cure Kids (curekids.org.nz)
- ^ Eva (curekids.org.nz)